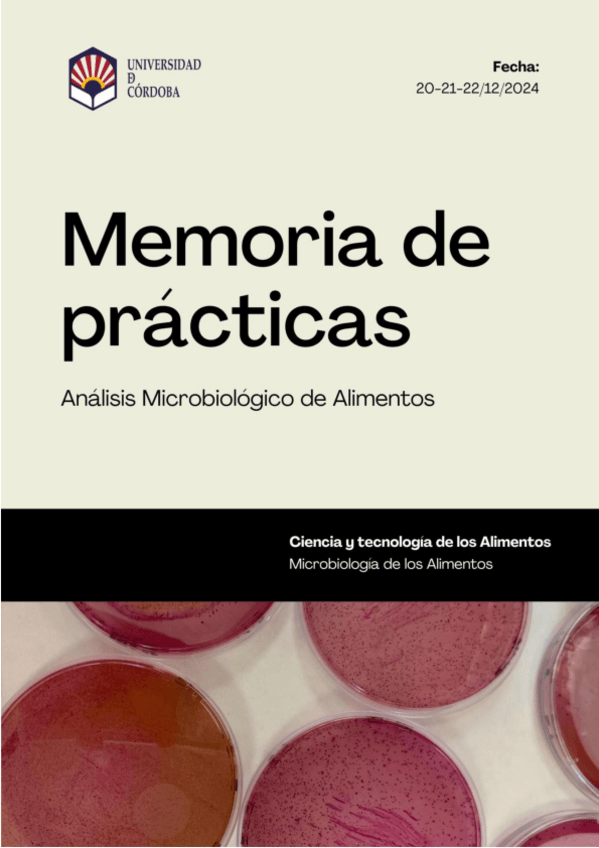

Microbiología de los Alimentos
He publicado nuevos examenes de 2º Microbiología de los Alimentos: Examen-micro.pdf
He publicado nuevos apuntes de 2º Microbiología de los Alimentos: apuntes-segundo-parcial.pdf
He publicado nuevos apuntes de 2º Microbiología de los Alimentos: apuntes-primer-parcial.pdf
He publicado nuevos apuntes de 2º Microbiología de los Alimentos: seminario-de-seguridad-alimentaria.pdf
Apuntes de microbiología de los alimentos. En verdad creo que este profesor se ha jubilado para el año que viene, pero si el contenido y las diapositivas son las mismas esto ayuda mucho.
Tablas resúmenes de los microorganismos, virus, parásitos, bacterias de los últimos 15 temas
Con esta cuadrilla impresa es más fácil responder las preguntas test tal y como se responden en los exámenes oficiales.
Con esta cuadrilla impresa es más fácil corregir los intentos de resolver las preguntas test.
He publicado nuevos examenes de 1º Microbiología de los Alimentos: Preguntas-Tipo-Test-de-Examenes-de-Microbiologia.pdf
He publicado nuevos apuntes de 3º Microbiología de los Alimentos: Apunts-2n-Parcial.pdf
He publicado nuevos apuntes de 3º Microbiología de los Alimentos: Taules-GRAM-Positiu-i-Negatiu.pdf
He publicado nuevos examenes de 3º Microbiología de los Alimentos: TEST-EXAMEN-RESOLT.pdf
He publicado nuevos apuntes de 3º Microbiología de los Alimentos: Taules-resum-1r-Parcial.pdf
apuntes
-
microbiología de los alimentos
Resumenes microbiología
He publicado nuevos apuntes de 3º Microbiología de los Alimentos: MDA-Tema-2.pdf
He publicado nuevos apuntes de 3º Microbiología de los Alimentos: MDA-Tema-1.pdf
He publicado nuevos apuntes de 3º Microbiología de los Alimentos: MDA-Glosari-2n-Parcial.pdf
apuntes
-
MDA Taules
He publicado nuevos apuntes de 3º Microbiología de los Alimentos: MDA Taules
He publicado nuevos examenes de 3º Microbiología de los Alimentos: 2n-parcial-2026.jpeg
He publicado nuevos examenes de 3º Microbiología de los Alimentos: 2n-PARCIAL.pdf
He publicado nuevos apuntes de 3º Microbiología de los Alimentos: Repas-Dolo-2n-Parcial.pdf
He publicado nuevos apuntes de 3º Microbiología de los Alimentos: Resum-micro.pdf
He publicado nuevos examenes de 3º Microbiología de los Alimentos: TEST-2n-Parcial.pdf
He publicado nuevos apuntes de 3º Microbiología de los Alimentos: 2n-parcial-micro.pdf
He publicado nuevos apuntes de 4º Microbiología de los Alimentos: Tema-12.-Seguridad-alimentaria.pdf
He publicado nuevos apuntes de 4º Microbiología de los Alimentos: Criterios-microbiologicos-y-programas-de-muestreo.pdf
He publicado nuevos apuntes de 4º Microbiología de los Alimentos: Tema-10.-Frutas-verduras-y-granos.pdf
He publicado nuevos apuntes de 4º Microbiología de los Alimentos: Tema-9.-Leche-y-derivados.pdf
He publicado nuevos apuntes de 4º Microbiología de los Alimentos: Tema-8.-Carne-y-pescado.pdf
He publicado nuevos apuntes de 4º Microbiología de los Alimentos: TEMAS-METODOS-QUIMICOS-Y-BIOLOGICOS.pdf
apuntes
-
Apunts micro
He publicado nuevos apuntes de 3º Microbiología de los Alimentos: Apunts micro
apuntes
-
TEORÍA 2025-2026
He publicado nuevos apuntes de 4º Microbiología de los Alimentos: TEORÍA 2025-2026
He publicado nuevos apuntes de 4º Microbiología de los Alimentos: Tema-6.-Vibrio-Cronobacter-y-Aeromonas.pdf
He publicado nuevos apuntes de 2º Microbiología de los Alimentos: MICRO-ALIMENTOS-ENTERO.pdf
He publicado nuevos apuntes de 1º Microbiología de los Alimentos: Microbiologia-1oparcial.pdf
apuntes
-
SEGUNDO PARCIAL
Esquemas de las alteraciones del segundo parcial y seminario: Seguridad de la cadena alimentaria UE
He publicado nuevos apuntes de 3º Microbiología de los Alimentos: PROCEDIMENT-CONTROL-DE-QUALITAT-MICROBIOLOGIC.pdf
He publicado nuevos examenes de 5º Microbiología de los Alimentos: Preguntas-2-parcial-por-temas.pdf
He publicado nuevos apuntes de 3º Microbiología de los Alimentos: MicroAlimentsTEMA18.pdf
He publicado nuevos apuntes de 3º Microbiología de los Alimentos: MicroAlimentsTEMA14.pdf
He publicado nuevos apuntes de 3º Microbiología de los Alimentos: MicroAlimentsTEMA13.pdf
He publicado nuevos apuntes de 3º Microbiología de los Alimentos: MicroAlimentsTEMA12.pdf
He publicado nuevos apuntes de 3º Microbiología de los Alimentos: MicroAlimentsTEMA11.pdf
He publicado nuevos apuntes de 3º Microbiología de los Alimentos: MicroAlimentsTEMA10.pdf
He publicado nuevos apuntes de 3º Microbiología de los Alimentos: examen-2n-parcial-pregunta-1.pdf
He publicado nuevos practicas de 2º Microbiología de los Alimentos: Practica-de-Microbiologia-de-los-Alimentos.pdf
He publicado nuevos apuntes de 3º Microbiología de los Alimentos: Casos-practics-protocol-microbiologic.docx
He publicado nuevos apuntes de 3º Microbiología de los Alimentos: Resum-aliments-MA-P2.pdf
He publicado nuevos apuntes de 3º Microbiología de los Alimentos: Resum-MA-P2.pdf
He publicado nuevos trabajos de 2º Microbiología de los Alimentos: INFORME-DE-LABORATORIO-23-24.pdf
trabajos
-
TRABAJO DE INVESTIGACION 23-24
He publicado nuevos trabajos de 2º Microbiología de los Alimentos: TRABAJO DE INVESTIGACION 23-24
He publicado nuevos apuntes de 3º Microbiología de los Alimentos: Bloc-D-Resum-aliments.pdf